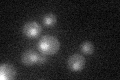
YKL038W
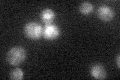
YKL038W

View description
Glucose-responsive transcription factor that regulates expression of several glucose transporter (HXT) genes in response to glucose; binds to promoters and acts both as a transcriptional activator and repressor
Localization:
Intensity:
Fold change:
Significance:
-
C’ GFP library in SD
nucleus20.76 -
N' NOP1pr-GFP in SD

nucleus64.0771 -
N' TEF2pr-mCherry in SD

nucleus29.5378 -
N' NATIVEpr-GFP in SD

nucleus24.0169 -
N' TEF2pr-VC and Cyto-VN in SD

nucleus33.6285 -
C’ GFP library in SD+DTT

nucleus22.121.06No -
C’ GFP library in SD+H2O2
nucleus23.891.15No -
C’ GFP library in Starvation Media

nucleus20.210.97No -
C’ GFP library on the background of Pup2-DaMP

nucleus -
C’ GFP library on the background of CCT mutant

nucleus20.17010.971222No
